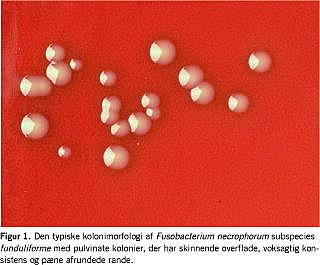

André Lemierre introducerede i 1936 begrebet anaerob postanginal septikæmi om disseminerede Fusobacterium necrophorum-infektioner, der udgik fra oropharynx [1]. Siden 1980'erne er betegnelsen Lemierres syndrom blevet brugt om metastaserende F. necrophorum-infektioner med primært fokus i hoved-hals-regionen. Gennem de seneste år er det dokumenteret, at F. necrophorum også kan give anledning til et spektrum af lokaliserede infektioner, især i hoved-hals-regionen.
Lokaliserede F. necrophorum-infektioner
F. necrophorum kan forårsage følgende lokaliserede sygdomsmanifestationer:
-
Akut solitær glandelabsces på halsen ses hos småbørn [2].
-
Otitis media, især af recidiverende karakter med ildelugtende flåd og smørsyrelugt, ses ligeledes hos småbørn [2-4].
-
Unge får peritonsillær absces, hvor F. necrophorum spiller en rolle i mindst 20% af tilfældene, formentlig langt flere [2, 5].
-
Hos unge med bakteriel tonsillitis findes F. necrophorum i op til 20%. Dette er mest udtalt ved recidiverende tonsillitis og især i symbiose med hæmolytiske gruppe C-streptokokker (GCS) [2, 6-8]. F. necrophorum påvises som regel i stor mængde hos patienterne.
-
Voksne i alderen 30-50 år kan få recidiverende sinuitis eller tandinfektion [2, 4].
-
Hos voksne i alderen 30-50 år ses også bløddelsinfektioner i hud og subcutis overalt på kroppen [2].
Behandling af lokaliserede F. necrophorum-infektioner
F. necrophorum er følsom over for penicillin, metronidazol samt clindamycin, mens der er lav følsomhed over for makrolider og kinoloner, som ikke bør anvendes [4, 9, 10].
Den optimale behandling af tonsillitis, otitis og sinuitis, der er forårsaget af F. necrophorum, er endnu uafklaret. Peroral antibiotisk behandling med penicillin kombineret med metronidazol i to uger, alternativt clindamycin i to uger, ser ud til at gøre patienter med F. necrophorum-tonsillitis raske. Der ses dog recidiver med ovenstående behandling. Formentlig kan antibiotisk behandling forhindre, at tilstanden udvikler sig til Lemierres syndrom. Ved peritonsillær absces er kirurgi vigtig, og antibiotika synes ikke at være nødvendig. Glandelabsces hos småbørn kræver formentlig både incision og antibiotisk behandling i 1-2 uger.
Lemierres syndrom
Hvert år ses i Danmark mindst 20 tilfælde af Lemierres syndrom - fortrinsvis hos tidligere raske personer som følger:
-
Otogen variant af Lemierres syndrom ses hos småbørn med akut førstegangs-otitis media [3, 9]. Børnene er som regel lidt yngre end de, der kun får lokaliseret F. necrophorum-øreinfektion. Der ses spredning til mastoidet og evt. meningitis, mens metastasering til lungerne er sjælden. F. necrophorum er som oftest den eneste patogene bakterie, der påvises ved dyrkning.
-
Hos unge ses udvikling af det klassiske Lemierres syndrom, der begynder med en akut tonsillitis, efterfulgt af tromboflebitis af vena jugularis interna med unilateral ømhed langs musculus sternocleidomastoideus [4, 9]. Der foreligger ofte en negativ strep A-antigentest. Det vides ikke, om det afspejler, at patienter med tonsillitis, der er forårsaget af hæmolytiske gruppe A-streptokokker (GAS-tonsillitis), får penicillin, hvorved Lemierres syndrom eventuelt undgås, eller om Lemierres syndrom især rammer patienter med non-GAS-tonsillitis. En uges tid senere følger pludselig høj feber, pulmonale symptomer, unilateral hævelse på halsen og abdominale smerter. Metastaserende abscesser ses hyppigst lokaliseret til lungerne i form af infiltrater, pleuraempyem og lungeabscesser. Metastasering ses også i form af parafaryngeal absces, mediastinitis og meningitis, mens spredning til led-, knogle-, abdomen, bløddele og andre foci er sjældnere [4, 9]. En del tilfælde er tilsyneladende polymikrobielle infektioner. Især ses GCS som ledsagebakterie i såvel bloddyrkning, abscesmateriale som svælgpodning [9].
-
Hos voksne i alderen 30-50 år ses Lemierres syndrom udgående fra bihulerne eller tænderne efterfulgt af de samme komplikationer, som beskrevet under punkt 2 [9].
Solitære glandelabscesser på halsen og peritonsillær abscesser synes ikke at udvikle sig til Lemierres syndrom [2].
Lemierres syndrom har et klassisk sygdomsbillede, og diagnosen bør mistænkes hos unge patienter, der efter en uges tid med ondt i halsen pludselig får forværring med høj feber, lungesymptomer og unilateral hævelse på halsen [1, 4, 9]. Imidlertid er syndromet så sjælden, at det forbliver ukendt for mange læger. Derfor rejses mistanken ofte først, når F. necrophorum konstateres i bloddyrkning eller andet materiale.
Lemierres syndrom er en alvorlig infektion med rapid forværring over få timer, hvorfor hurtig diagnostik og behandling er vigtig. Laboratorieundersøgelser viser neutrofili med et forhøjet antal stavkernede neutrofile, klart forhøjet C-reaktivt protein samt eventuelt let forhøjet bilirubin, mens der som regel kun er mild påvirkning af dissemineret intravaskulær koagulation (DIC)-parametre [4, 9].

Behandling af Lemierres syndrom
Behandlingen bør foregå i et tæt tværfagligt samarbejde mellem:
-
Billeddiagnostisk Afdeling, hvor der skal være adgang til at få akutte computertomografier af abscesområder, især lunger og mediastinum.
-
Kirurgisk Afdeling, oftest thoraxkirurgisk med henblik på drænage af pleuraempyem, tilgængelige abscesser og drænage af mediastinum. Gentagne drænager er ofte påkrævet i det initiale forløb.
-
Intensiv Afdeling, da respirator og intensiv terapi ofte er påkrævet initialt.
-
Infektionsmedicinsk og Mikrobiologisk Afdeling, der som hovedregel iværksætter intravenøs kombinationsbehandling med penicillin G 2-5 MIE × 4 daglig plus metronidazol 500 mg × 3 daglig [9, 10]. Ved f.eks. penicillinallergi er clindamycin 600 mg × 3 daglig et go dt alternativ. Overgang til peroral behandling bør først ske, når der er sikker klinisk effekt og klart fald i inflammationsparametre. Som regel kræves minimum 4-6 ugers antibiotisk behandling. Patienterne har ofte langvarig feber - selv efter at de er påbegyndt korrekt antibiotisk behandling.
Antikoagulationsbehandling er tvivlsom og komplicerer kirurgiske indgreb, hvorfor det kun anbefales i tilfælde af retrograd trombose af sinus cavernosus. Hyperbar oxygenering har været anvendt i enkelte tilfælde, men kan være vanskelig at gennemføre hos disse svært syge patienter. I Danmark har kun Rigshospitalet et trykkammer, hvor personale kan være til stede i kammeret.
Lemierres syndrom forårsager ofte ugelange indlæggelser og langvarig rekonvalescens. Der er op til 9% mortalitet, og yderligere omkring 9% får varige sequelae i form af nedsat lungefunktion og cerebrale sequelae [9]. F. necrophorum meningitis har en mortalitet på op til 30% trods sufficient antibiotisk behandling, og op mod halvdelen af dem, der overlever, får permanente cerebrale sequelae [4]. Både morbiditet og mortalitet er relateret til omfang og beliggenhed af de metastaserende abscesser, ligesom såvel patient som lægelig delay øger risikoen for komplikationer, hvilket accentuerer vigtigheden af at stille diagnosen så tidligt som muligt [4, 9].
Andre disseminerede F. necrophorum-infektioner
Hos ældre med disponerende lidelser ses F. necrophorum-infektioner, der udgår fra gastrointestinalkanalen og/eller urogenitalkanalen. En stor procentdel af disse patienter har konkurrerende lidelser, ofte cancer, der er relateret til det primære infektionsfocus [9]. Dissemineret F. necrophorum-infektion i denne aldersgruppe bør derfor altid medføre udredning for cancer. Metastaserende infektion til lungerne er sjælden, og den antibiotiske behandling er som regel ukompliceret. Alder og konkurrerende lidelser er derimod medvirkende til en høj mortalitet på 26% [9].
Mikrobiologi
Statens Seruminstituts (SSI) almindelige anaerobe chokoladeplade er ikke velegnet til at finde F. necrophorum, der er relativt langsomtvoksende og derfor let bliver overgroet af andre bakterier i prøvemateriale fra slimhinder. En selektiv anaerob agarplade, f.eks. SSI's anaerobe agarplade, tilsat nalidixin 5,0 mg/l og vancomycin 2,5 mg/l, og inkuberet anaerobt i 10% CO2 og 10% brint i op til fire dage, er derimod god til at finde vækst af F. necrophorum [10]. Den typiske kolonimorfologi er vist i Figur 1. En tidlig mistanke om F. necrophorum subspecies funduliforme fås ud fra det karakteristiske mikroskopifund i gramfarvning. Her ses kokkoide/pleomorfe stave, der ikke er fusiforme (tenformede), men ligger i tråde og nøgler (Figur 2). Mistanken om F. necrophorum bør straks videregives til klinikerne. Hvis der »kun« meddeles, at der er fundet »vækst af anaerobe gramnegative bakterier« i f.eks. bloddyrkning uden fremhævelse af den karakteristiske pleomorfe morfologi i mikroskopien, kan klinikerne forledes til at søge efter et abdominalt focus, ikke mindst da en del patienter med klassisk Lemierres syndrom har abdominale smerter [9]. Gennem nogle få supplerende test kan en endelig identifikation foreligge inden for tre dage [10]. En daglig polymerasekædereaktion (PCR)-analyse er selvfølgelig hurtigere, men er forholdsvis dyr og giver ikke antibiotikafølsomheden. F. necrophorum er normalt fuldt følsom for penicillin, metronidazol og clindamycin. Penicillinresistens ses dog, men er sjælden.
F. necrophorum kan opdeles i to subspecies (subsp.): funduliforme og necrophorum. I nye undersøgelser fastslås det, at det næsten udelukkende er subsp. funduliforme, der ses i humane infektioner, både de lokaliserede og de disseminerede [10].
F. necrophorum subsp. funduliforme er en del af normalfloraen i oropharynx [8, 10] og måske også i gastrointestinal- og urogenitalkanalen [1]. Vi ved endnu ikke, hvorfor F. necrophorum pludselig bliver invasiv. Man har gisnet om, at forudgående viral infektion, f.eks. mononukleose, eller bakteriel orofaryngeal infektion, f.eks. med GCS, kunne fremme dens invasion og/eller skabe optimale forhold for etablering af en anaerob infektion. F. necrophorum er dog ret aerotolerant, hvilket ikke er så overraskende, når den primært findes i halsen.
Vi ved ikke, om F. necrophorum, ligesom f.eks. Neisseria meningitidis, specielt ved den første kontakt giver risiko for dis-semineret infektion, mens man som svælgbærer udvikler en form for immunitet. Det kan også være, at kun »udvalgte« patienter med f.eks. trombofilitendens eller komplementdefekter udvikler Lemierres syndrom, eller måske er det kun udvalgte F. necrophorum subsp. funduliforme -stammer, der er patogene f.eks. i kraft af at være i stand til at undgå komplementsystemet [4, 9].
Mens bloddyrkninger, pus fra normalt sterile foci og fra abscesser rutinemæssigt dyrkes såvel aerobt som anaerobt, inkuberes svælgpodninger og ørepodninger som regel ikke anaerobt på de mikrobiologiske afdelinger i Danmark. Man bør formentlig anbefale, at alle unge mellem ti år og 40 år med tegn på bakteriel tonsillit og negativ strep A-antigentest (akut og recidiverende non-GAS-tonsillit) får indsendt svælgpodning til anaerob dyrkning på selektiv anaerob agarplade udover vanlig aerob dyrkning. Ligeledes bør man formentlig anbefale, at alle børn med recidiverende og kronisk otitis media får indsendt ørepodning og/eller pus fra mellemøret til såvel aerob som supplerende anaerob undersøgelse.
Lena Hagelskjær Kristensen, Klinisk Mikrobiologisk Afdeling, Regionshospitalet Viborg, DK-8800 Viborg. E-mail: lena.h.kristensen@viborg.rm.dk
Antaget: 23. oktober 2008
Interessekonflikter: Ingen
- Lemierre A. On certain septicaemias due to anaerobic organisms. Lancet 1936;1:701-3.
- Hagelskjaer Kristensen L, Prag J. Localised Fusobacterium necrophorum infections: a p rospective laboratory-based Danish study. Eur J Clin Microbiol Infect Dis 2008;27:733-9.
- Le MA, Jamet A, Carbonnelle E et al. Fusobacterium necrophorum middle ear infections in children and related complications: Report of 25 cases and literature review. Pediatr Infect Dis J 2008;27:613-7.
- Riordan T. Human infection with Fusobacterium necrophorum (Necrobacillosis), with a focus on Lemierre's syndrome. Clin Microbiol Rev 2007;20:622-59.
- Jousimies-Somer H, Savolainen S, Makitie A et al. Bacteriologic findings in peritonsillar abscesses in young adults. Clin Infect Dis 1993;16:S292-S298.
- Batty A, Wren MW, Gal M. Fusobacterium necrophorum as the cause of recurrent sore throat: comparison of isolates from persistent sore throat syndrome and Lemierre's disease. J Infect 2004;51:299-305.
- Batty A, Wren MW. Prevalence of Fusobacterium necrophorum and other upper respiratory tract pathogens isolated from throat swabs. Brit J biomed sci 2005;62:66-70.
- Jensen A, Hagelskjaer Kristensen L, Prag J. Detection of Fusobacterium necrophorum subsp. funduliforme in tonsillitis in young adults by real-time PCR. Clin Microbiol Infect 2007;13:695-701.
- Hagelskjaer Kristensen L, Prag J. Lemierre's syndrome and other disseminated Fusobacterium necrophorum infections in Denmark: a prospective epidemiological and clinical survey. Eur J Clin Microbiol Infect Dis 2008;27:779-89.
- Jensen A, Hagelskjaer Kristensen L, Nielsen H et al. Minimum requirements for a rapid and reliable routine identification and antibiogram of Fusobacterium necrophorum . Eur J Clin Microbiol Infect Dis 2008;27:557-63.
<ol class="Litt-list">
<li>Lemierre A. On certain septicaemias due to anaerobic organisms. Lancet 1936;1:701-3.</li>
<li>Hagelskjaer Kristensen L, Prag J. Localised <span class="Emphasis" type="Regular">Fusobacterium necrophorum</span> infections: a prospective laboratory-based Danish study. Eur J Clin Microbiol Infect Dis 2008;27:733-9.</li>
<li>Le MA, Jamet A, Carbonnelle E et al. <span class="Emphasis" type="Regular">Fusobacterium necrophorum</span> middle ear infections in children and related complications: Report of 25 cases and literature review. Pediatr Infect Dis J 2008;27:613-7.</li>
<li>Riordan T. Human infection with <span class="Emphasis" type="Regular">Fusobacterium necrophorum</span> (Necrobacillosis), with a focus on Lemierre's syndrome. Clin Microbiol Rev 2007;20:622-59.</li>
<li>Jousimies-Somer H, Savolainen S, Makitie A et al. Bacteriologic findings in peritonsillar abscesses in young adults. Clin Infect Dis 1993;16:S292-S298.</li>
<li>Batty A, Wren MW, Gal M. <span class="Emphasis" type="Regular">Fusobacterium necrophorum</span> as the cause of recurrent sore throat: comparison of isolates from persistent sore throat syndrome and Lemierre's disease. J Infect 2004;51:299-305.</li>
<li>Batty A, Wren MW. Prevalence of <span class="Emphasis" type="Regular">Fusobacterium necrophorum</span> and other upper respiratory tract pathogens isolated from throat swabs. Brit J biomed sci 2005;62:66-70.</li>
<li>Jensen A, Hagelskjaer Kristensen L, Prag J. Detection of <span class="Emphasis" type="Regular">Fusobacterium necrophorum subsp. funduliforme</span> in tonsillitis in young adults by real-time PCR. Clin Microbiol Infect 2007;13:695-701.</li>
<li>Hagelskjaer Kristensen L, Prag J. Lemierre's syndrome and other disseminated <span class="Emphasis" type="Regular">Fusobacterium necrophorum</span> infections in Denmark: a prospective epidemiological and clinical survey. Eur J Clin Microbiol Infect Dis 2008;27:779-89.</li>
<li>Jensen A, Hagelskjaer Kristensen L, Nielsen H et al. Minimum requirements for a rapid and reliable routine identification and antibiogram of <span class="Emphasis" type="Regular">Fusobacterium necrophorum</span> . Eur J Clin Microbiol Infect Dis 2008;27:557-63.</li>
</ol>
Summary Fusobacterium necrophorum: From tonsillitis to Lemierre's syndrome Ugeskr Læger 2009;171(12):987-990 Fusobacterium necrophorum plays a role in non-GAS-tonsillitis in adolescents and probably also in small children with recurrent otitis media. Anaerobic culture on selective anaerobic media is recommended to detect F. necrophorum and treat such patients. Denmark sees at least 20 annual cases of Lemierre's syndrome with a mortality reaching 9%. Early suspicion of Lemierre's syndrome in adolescents with non-GAS-tonsillitis, who develop septicaemia, pulmonary symptoms and unilateral swelling on the neck, is mandatory to lower morbidity and mortality.